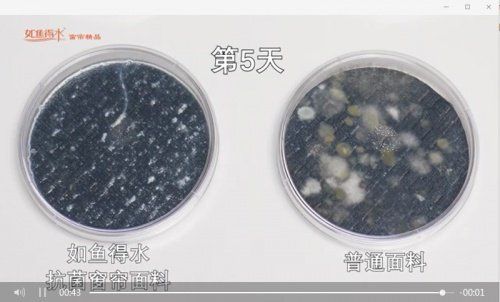

叶一茜惊喜助阵如鱼得水窗帘精品直播间,当晚C位竟然是它?
健康生活来自用心
——宠粉,用福利说话
幸福与健康,是每个人的追求,也是永远紧密相连、相辅相成的,尤其这两年的疫情影响,更加凸显了健康生活对于国人追求幸福的重要性。在这样的背景下,如鱼得水窗帘以幸福与健康为源点,以国际幸福日为契机,在3月13日晚上19:30,开启一场以“320国际幸福日——拉开健康新生活”为主题的花式宠粉大战,不仅举办了全程福利的线上直播,还在线下联动了全国终端门店开展了“以旧换新”的环保公益活动,高品质抗菌窗帘成为当晚绝对C位。

在直播中,健康生活推荐官叶一茜热心分享自己的幸福配方,并带来明星同款窗帘限时秒杀福利,引发一波下单狂潮;如鱼得水总裁陈道贤空降直播间实力宠粉,红包、礼品轮番上阵,在线网友直呼过瘾;此外,新品抗菌窗帘优惠超大,多重福利享不停……此次直播吸引了大量粉丝围观,来自全国各地的新老客户,深深感受到了与如鱼得水窗帘一起拉开健康新生活的幸福感。

(明星同款产品:锦绣前程-米灰)
健康生活来自安全
——抗菌,用科学说话
健康早已成为现代家居生活方式的重要标准,我们每天呆在家里至少10小时以上,疫情下居家时间更长,因此室内环境健康至关重要。此次直播活动重点推介的如鱼得水爆款新品,也是明星叶一茜家中的同款——拥有高达99%抗菌品质的如鱼得水抗菌窗帘正是为此诞生的。

健康不容怠慢,居住安全才能幸福。生活中的细菌无处不在,很多家庭每周或者每个月都会更换床品,但是窗帘作为家里与外界接触的第一道防线,很少有人会经常清洗,风吹日晒很容易沾染灰尘,这时候一款抗菌窗帘就非常重要。尤其是家里有孩子、孕妇的家庭,一款抗菌窗帘给带给家人更安心、更放心的环境。针对窗帘抗菌的重要性和必要性,杭州市三甲医院儿科主任医师冯亚男亲临直播间,带领大家观看了一段抗菌挑战视频。

视频中,将牛奶和糖水混合后分别倒在如鱼得水抗菌窗帘面料和普通面料上,在同样的环境下,经历5天的实验观察后可以发现,如鱼得水抗菌窗帘面料始终没有变化,没有产生任何霉菌,而普通面料发生了明显的霉变反应,上班布满霉菌,两者对比触目惊心。
抗菌挑战视频截图
“抗菌”指的就是如鱼得水使用的“抗菌功能面料”,在实验室测试条件下,针对金黄色葡萄球菌(肺炎、肠炎)、大肠杆菌(腹泻、败血症)、肺炎克雷伯氏菌(急性肺炎)等细菌的抗菌率可高达99%。如鱼得水抗菌窗帘采用的是银离子物理抗菌技术,医学研究表明,银是天然抗生素,可以杀灭650余种细菌和病毒,而且其杀菌能力在数千年前就已经被人类发现和应用了,高效又安全。就算不常清洗窗帘,宝贝也能自由放心地在窗边玩躲猫猫。

健康生活来自品质
——工艺,用数据说话
直播中反复提到的工艺,也是吸引叶一茜选择如鱼得水的第一眼原因——成就如鱼得水窗帘高颜值和高品质的西装工艺,正是如鱼得水窗帘闻名业界的重要原因。西装制作工艺代表了纺织制作工艺的极高水平,如鱼得水采用了313道工序标准保证窗帘做工,从打版裁剪到针迹笔直、到针码间距、到机针选用,再到拼接工艺和侧边处理......为了体现线迹的美感和增加缝制的紧牢度,针码每寸标准12针;窗帘侧边上下一律4厘米宽,误差不超过2毫米;拼缝的布边全部采用锁包一体工艺......为了确保准确性,叶一茜现场参与了测量,最终得出的数据毫无争议。

健康生活来自睡眠
——助眠,用事实说话
睡眠是人类生活中必不可缺的一种正常生理现象,睡好觉同样是迈向健康的一大步。窗帘在家居装饰中起着非常重要的作用,特别是卧室中,睡眠的好坏跟窗帘有着分不开的联系。如鱼得水窗帘兼具物理遮光、隔音降噪、保温隔热等功能,堪称睡好觉的最佳助眠师。

如鱼得水窗帘直播间在开始就温馨提示了,光刺激对儿童睡眠的重要影响,孩子在白天睡觉时应该尽量避免一切光刺激。如鱼得水窗帘内缝遮光丝物理遮光,将灼热紫外线拦在窗外,不含有害遮光图层更健康,遮光效果高达90%;降音隔噪也是睡好觉的重要保障,如鱼得水窗帘面料厚实、克重量高,能够很好地起到隔音降噪的效果,再也不需要忍受“马路噪音”;冬暖夏凉,维持适宜的室内温度,如鱼得水窗帘在保温隔热上也有非常好的效果。
在直播过程中,推荐官叶一茜和总裁陈道贤都给出了选择如鱼得水窗帘的理由,主要关键词就是抗菌、遮光、垂感和质量,叶一茜甚至现场参与了垂感检测。无论如何“蹂躏”,依旧垂顺有型。利用物理高温的方式进行杀菌定型处理,如鱼得水除菌窗帘不用外力支撑、无需熨烫打理就可以保持独立形态,同时还能消除静电,杀菌消毒。

正如总裁陈道贤所说,窗帘相当于家的口罩,十分重要。如鱼得水28年来专注只做一件事——做窗帘,如今为了进一步提高“口罩”的防御效果,如鱼得水推出了高品质抗菌窗帘,用科学手段为健康生活加分。直播活动虽然结束了,但如鱼得水窗帘的责任和使命还在继续。关爱家人健康,提升品质生活,如鱼得水320幸福日的活动仍在火热进行中,一起用抗菌窗帘拉开健康新生活吧!

网址:叶一茜惊喜助阵如鱼得水窗帘精品直播间,当晚C位竟然是它? https://www.jiaju82.com/news-view-id-800582.html

